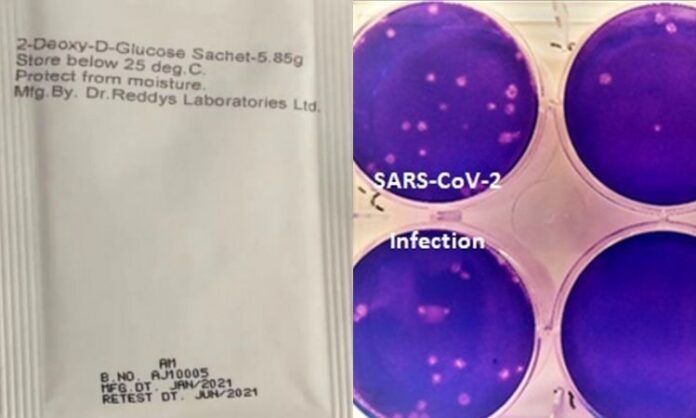
2-DG

नई दिल्ली: देश में कोरोना वायरस की दूसरी लहर का कहर के बीच संक्रमण के खिलाफ जंग लगातार जारी है। कोरोना को हराने के लिए जहां वैक्सीनेशन प्रक्रिया को और तेज करने का आदेश है, वहीं कोरोना से लड़ने के लिए DRDO की ओर से विकसित कोरोना की दवा 2-DG की पहली खेप लॉन्च की गई। रक्षा मंत्री राजनाथ सिंह और स्वास्थ्य मंत्री डॉ. हर्षवर्धन ने इस दवा को लॉन्च किया। लॉन्चिंग के बाद यह दवा अगले एक-दो दिनों में मरीजों को मिलने की संभावना है। बताया जा रहा है कि हैदराबाद की डॉक्टर रेड्डीज लैब में इसकी 10 हजार डोज बनकर तैयार हो गई है।
बता दें हैदराबाद स्थित डॉ. रेड्डीज लेबोरेटरीज के सहयोग से रक्षा अनुसंधान एवं विकास संगठन (DRDO) की प्रयोगशाला इंस्टीट्यूट ऑफ न्यूक्लियर मेडिसिन एंड एलाइड साइंसेज (INMAS) द्वारा दवा 2-डिऑक्सी-डी-ग्लूकोज (2-DG) का एक एंटी-COVID-19 चिकित्सकीय अनुप्रयोग विकसित किया गया है। परीक्षण परिणामों से पता चला है कि यह अणु अस्पताल में भर्ती रोगियों की तेजी से रिकवरी में मदद करता है एवं बाहर से ऑक्सीजन देने पर निर्भरता को कम करता है। अधिक मात्रा में COVID रोगियों के 2-DG के साथ इलाज से उनमें RTPCR नकारात्मक रूपांतरण देखा गया।
2-DG COVID-19 से पीड़ित लोगों के लिए काफी फायदेमंद होगी। महामारी के विरुद्ध तैयारी के लिए प्रधानमंत्री श्री नरेन्द्र मोदी के आह्वान के सिलसिले में रक्षा अनुसंधान एवं विकास संगठन (DRDO) ने 2-DG के एंटी-COVID चिकित्सकीय अनुप्रयोग विकसित करने की पहल की। अप्रैल 2020 में महामारी की पहली लहर के दौरान,आईएनएमएएस-DRDO के वैज्ञानिकों ने हैदराबाद स्थित सेंटर फॉर सेलुलर एंड मॉलिक्यूलर बायोलॉजी (CCMB) की मदद से प्रयोगशाला परीक्षण किए और पाया कि यह दवा SARS-COV-2 वायरस के खिलाफ प्रभावी ढंग से काम करती है और वायरल बढ़ने को रोकती है। इन परिणामों के आधार पर ड्रग्स कंट्रोलर जनरल ऑफ इंडिया (DCGI) सेंट्रल ड्रग्स स्टैंडर्ड कंट्रोल ऑर्गनाइजेशन (CDSCO) ने मई 2020 में COVID-19 रोगियों में 2-DG के चरण-2 के नैदानिक परीक्षण की अनुमति दी।
DRDO ने अपने उद्योग सहयोगी DRL हैदराबाद के साथ मिलकर COVID-19 मरीजों में दवा की सुरक्षा और प्रभावकारिता का परीक्षण करने के लिए नैदानिक परीक्षण शुरू किए। मई से अक्टूबर 2020 के दौरान किए गए चरण- II परीक्षणों (डोज़ रेजिंग समेत) में दवा COVID-19 रोगियों में सुरक्षित पाई गई और उनकी रिकवरी में महत्वपूर्ण सुधार दिखाया गया। दूसरे चरण का संचालन छह अस्पतालों में किया गया और देश भर के 11 अस्पतालों में फेज II बी (डोज रेजिंग) क्लीनिकल ट्रायल किया गया। फेज-2 में 110 मरीजों का ट्रायल किया गया।
प्रभावकारिता की प्रवृत्तियों में 2-DG के साथ इलाज किए गए रोगियों ने विभिन्न एंडपॉइंट्स पर स्टैंडर्ड ऑफ केयर (SOC) की तुलना में तेजी से रोगसूचक उपचार प्रदर्शित किया। इस उपचार के दौरान रोगी के शरीर में विशिष्ट महत्वपूर्ण संकेतों से संबंधित मापदंड सामान्य बनाने में लगने वाले औसत समय में SOC की तुलना में एक बढ़िया अंतर देखा गया।
सफल परिणामों के आधार पर डीसीजीआई ने नवंबर 2020 में चरण-3 नैदानिक परीक्षणों की अनुमति दी। दिल्ली,उत्तर प्रदेश,पश्चिम बंगाल, गुजरात, राजस्थान, महाराष्ट्र, आंध्र प्रदेश, तेलंगाना, कर्नाटक और तमिलनाडु के 27 COVID अस्पतालों में दिसंबर 2020 से मार्च 2021 के बीच 220 मरीजों पर फेज-3 क्लीनिकल ट्रायल किया गया। तीसरे चरण के क्लीनिकल ट्रायल के विस्तृत आंकड़े डीसीजीआई को पेश किए गए। 2-DG के मामले में रोगियों के लक्षणों में काफी अधिक अनुपात में सुधार देखा गया और SOC की तुलना में तीसरे दिन तक रोगी पूरक ऑक्सीजन निर्भरता (42 प्रतिशतबनाम 31 प्रतिशत) से आज़ाद हो गए जो ऑक्सीजन थेरेपी/ निर्भरता से शीघ्र राहत का संकेत है।
इसी तरह का रुझान 65 साल से अधिक उम्र के मरीजों में देखा गया । दिनांक 1 मई, 2021 को DCGI ने इस दवा के आपातकालीन उपयोग की गंभीर COVID-19 रोगियों में सहायक चिकित्सा के रूप में अनुमति प्रदान की। ग्लूकोज का एक सामान्य अणु और एनालॉग होने के नाते इसे आसानी से उत्पादित किया जा सकता है और देश में अधिक मात्रा में उपलब्ध कराया जा सकता है।
एक सैशे में पाउडर के रूप में यह दवा आती है जिसे पानी में घोलकर लिया जाता है। यह वायरस संक्रमित कोशिकाओं में जमा होती है और वायरल संश्लेषण और ऊर्जा उत्पादन को रोककर वायरस के विकास को रोकती है। वायरस से संक्रमित कोशिकाओं में इसका चयनात्मक संचय इस दवा को बेजोड़ बनाता है।
वर्तमान में जारी दूसरी COVID-19 लहर में बड़ी संख्या में मरीज गंभीर ऑक्सीजन निर्भरता का सामना कर रहे हैं और उन्हें अस्पताल में भर्ती होने की जरूरत है। संक्रमित कोशिकाओं में दवा के प्रभाव करने के तरीक़े के कारण इस दवा से बहुमूल्य जीवन बचाने की उम्मीद है। इससे COVID-19मरीजों के लिए अस्पताल में बिताए जाने वाले दिनों की संख्या भी कम हो जाती है।